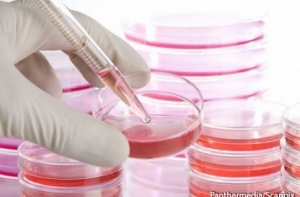

Читайте нас также
В подъездах многоквартирного дома на улице Лемеша 3 в Риге с конца января висят объявления Центра по контролю и профилактике заболеваний, согласно которым в одной из квартир обнаружены бактерии-возбудители легионеллеза, пишет портал rus.delfi.lv.
После эпидемиологического обследования, которое проводилось 16 января, в нагревателе воды, а также в образцах горячей и холодной воды в одной из квартир дома был обнаружен возбудитель легионеллеза - бактерии Legionella pneumophila. После этого в подъездах были размещены объявления (фото), в которых описывается ситуация и рассказывается о симптомах легионеллеза.
Как сообщила Delfi представитель обслуживающей дом компании Rīgas namu pārvaldnieks Инна Горбача, на одну ночь температуру нагрева воды в доме подняли до 70 градусов и в качестве профилактики запустили циркуляцию воды. RNP планирует организовать опрос среди жителей дома - согласятся ли они на очистку и дезинфекцию внутренней системы водоснабжения (общая стоимость 429 евро). По итогам опроса и будет принято решение по дальнейшим действиям.
Также имеется информация, что подобный случай зафиксирован в доме на улице Гоголя. Бактерия была обнаружена в квартире пожилой женщины, которая, скорее всего, из-за экономии, долгое время не пользовалась водой.
Легионеллез - болезнь, также известное как «болезнь легионеров», питтсбургская пневмония, понтиакская лихорадка, легионелла-инфекция, лихорадка форта Брэгг. Острое инфекционное заболевание, которое вызывают микроорганизмы рода Legionella, живущие на неживых объектах окружающей среды. Главным источником поражения легионеллой является застойная некипяченая вода как в природных водохранилищах, так и в искусственных сооружениях – резервуарах, водных установках, водонагревателях, системах отопления и кондиционирования воздуха.

Свое название «болезнь легионеров» получила из-за самой первой заметной вспышки заболевания - в 1976 году, во время съезда Американского легиона в Филадельфии (штат Пенсильвания, США). Тогда из 4000 участников съезда заболел 221 человек, 34 из них скончались. Позже врачи «вспомнили» и о других, более ранних и даже более масштабных эпидемиях «непонятной пневмонии», однако у болезни уже появилось название.
Существует более чем один вид легионеллеза, однако из-за сравнительной новизны болезни классификация пока не устоялась. Коротко говоря, «болезнь лигионеров», - это особо острая и опасная форма пневмонии. Разные виды болезни вызывают разные симптомы, характерные и для пневмонии: общая усталость, высокая (до 40 градусов) температура в течение нескольких дней, озноб, головная боль, головокружение, спутанность сознания. Учитывая, что сейчас в Латвии распространяется грипп, при появлении таких симптомов в любом случае необходимо обратиться к врачу. Напомним, что пневмония в сочетании с гриппом является смертельно опасным заболеванием, особенно для пожилых людей.
Заразиться легионеллезом можно только через дыхательные пути - вдыхая либо водяной пар (например, в душе, джакузи и т.д.), либо пыль. На съезде Американского легиона люди заболели, получив бактерию с воздухом из системы кондиционирования. Отмечены случаи заболевания при проведении земляных работ. Однако чаще всего люди заболевают, «подхватив» болезнь в душе или различных водных аттракционах в гостиницах или курортах. Наиболее подвержены болезни курящие мужчины-путешественники в возрасте после 40 лет, страдающие от диабета, сердечно-сосудистых заболеваний или болезней, при которых в курс лечения входят препараты, подавляющие иммунитет.
Случаев передачи легионеллеза от человека к человеку не выявлено. При общем сильном ослаблении организма заразиться можно и употребляя сырую воду вовнутрь, но для этого иммунная система должна быть по-настоящему сильно подавлена (поэтому такой вид легионеллеза часто называют «больничным»).
Болезнь легионеров не является чем-то таким, с чем латвийские медики и специалисты Латвийского центра инфектологии (ЛЦИ) не сталкивались бы ранее. Отдельные случаи заболевания были отмечены как минимум в 2005 году. Латвийцы также периодически «импортируют» болезнь из других стран, например, Таиланда. Впрочем, напомним, что хотя легионеллёз можно «привезти» с курорта, от человека к человеку он не распространяется - нет повода для паники, бойкота коллег-отпускников или непосещения родных в больнице.
Последняя крупная вспышка в Латвии была зарегистрирована в 2010-2011 годах. Сначала в ЛЦИ констатировали распространение болезни и признали, что один человек от нее скончался; затем уточнили, что за пять месяцев заболели 13 человек; и, наконец, нашли бактерию, вызывающую болезнь в водопроводе ряда рижских многоэтажек.










































































